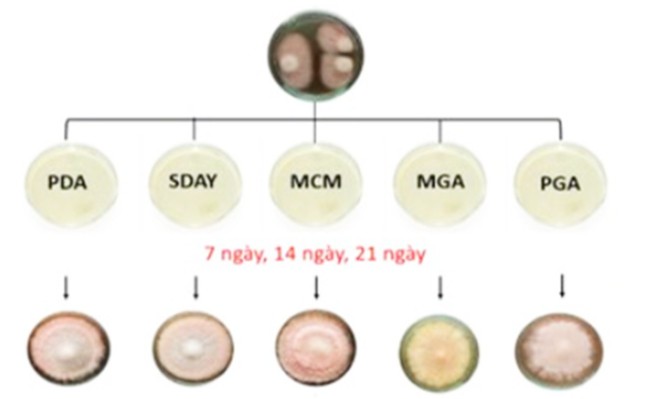

Phân lập thành công chủng nấm Monascus sp. phục vụ sản xuất gạo lên men đỏ
Mặc dù Việt Nam là một trong những quốc gia xuất khẩu gạo hàng đầu thế giới, phần lớn sản phẩm vẫn ở dạng thô, làm giảm giá trị kinh tế. Một trong những sản phẩm chế biến sâu đáng chú ý là gạo lên men đỏ (Red Yeast Rice - RYR), được tạo ra bằng cách lên men gạo với nấm Monascus purpureus thuộc chi nấm mốc Monascus sp.
Monascus sp. có khả năng tổng hợp các sắc tố sinh học tự nhiên thông qua quá trình sinh tổng hợp polyketide, tạo nên các nhóm sắc tố đỏ, cam và vàng với hoạt tính sinh học như chống oxy hóa, kháng khuẩn, kháng viêm, hỗ trợ điều hòa đường huyết, chống béo phì và bảo vệ tế bào thần kinh. Tuy nhiên, một số chủng Monascus sp. có thể sinh ra citrinin, loại độc tố vi nấm (mycotoxin) có khả năng gây tổn thương gan và thận. Do đó, trong sản xuất gạo đỏ lên men, cần lựa chọn các chủng Monascus sp. không sản sinh citrinin nhằm bảo đảm an toàn thực phẩm. Trung tâm Công nghệ sinh học TP. Hồ Chí Minh đã tiến hành phân lập chủng vi khuẩn Monascus sp. bản địa không sinh độc tố, có thể ứng dụng trong sản xuất gạo lên men đỏ giàu monacolin K - hợp chất hỗ trợ giảm cholesterol và bảo vệ tim mạch.
Nhóm nghiên cứu đã xác định được chín chủng có khả năng tổng hợp monacolin K cao và không tạo ra citrinin từ hơn 80 mẫu Monascus sp. tự nhiên. Quá trình định danh được thực hiện qua giải trình tự ITS LSU (vùng trình tự gen thường được sử dụng trong sinh học phân tử để định danh và phân loại vi sinh vật, đặc biệt là nấm và vi khuẩn), kết hợp phân tích MLSA (phương pháp phân tích trình tự nhiều gen để định danh và phân loại chính xác vi sinh vật).
Ngoài ra, các tác giả đã hoàn thiện quy trình sản xuất gạo lên men đỏ (với một trong chín chủng nấm được tuyển chọn) quy mô 5kg/mẻ, sản phẩm đầu ra ở dạng bột mịn, khô, tơi, màu đỏ tự nhiên, là nguyên liệu tiềm năng cho nhiều dòng thực phẩm chức năng hỗ trợ sức khỏe.
Kết quả kiểm nghiệm bằng LC-QTOF-MS/MS (kỹ thuật sắc ký lỏng ghép khối phổ phân giải cao) cho thấy, sản phẩm không chứa chất độc hại, vi sinh vật gây bệnh hay kháng sinh, bảo đảm an toàn sinh học. Ngoài ra, thử nghiệm trên chuột trắng cho thấy liều cao 2.000 mg/kg không gây độc cấp tính và không ảnh hưởng đến chức năng gan - thận, góp phần làm giảm triglyceride và tăng cholesterol tốt (HDL-C), hỗ trợ tích cực cho sức khỏe tim mạch.
Bên cạnh monacolin K, gạo lên men đỏ còn chứa nhiều hợp chất có lợi như flavonoid, sterol, acid béo không bão hòa và terpenoid, đều là những thành phần có vai trò tích cực trong việc kiểm soát cholesterol và bảo vệ hệ tim mạch.
Kết quả nghiên cứu mở ra triển vọng sử dụng các chủng Monascus sp. được tuyển chọn trong sản xuất gạo lên men đỏ, giúp chủ động nguồn nguyên liệu trong nước và giảm phụ thuộc nhập khẩu.
https://www.vista.gov.vn/vi/news/khoa-hoc-nong-nghiep/phan-lap-thanh-cong-chung-nam-monascus-sp-phuc-vu-san-xuat-gao-len-men-do-12014.html
- Quercetin và tinh dầu ớt giúp bảo quản cá tra khô lâu hơn (02/10/2025)
- Không ngừng đổi mới sáng tạo, đưa đất nước phát triển giàu mạnh trong kỷ nguyên mới (01/10/2025)
- Tổng Bí thư nhấn mạnh ba trụ cột then chốt với ngành khoa học và công nghệ (01/10/2025)
- Bộ Khoa học và Công nghệ được trao tặng Huân chương Lao động hạng Nhất (01/10/2025)
- KHCN, đổi mới sáng tạo và CĐS không chỉ là lựa chọn, mà là con đường sống còn để phát triển nhanh và bền vững (30/09/2025)
- Sửa đổi Luật Chuyển giao công nghệ: Cuộc sửa đổi toàn diện (30/09/2025)
- Hướng điều trị tiềm năng cho ung thư não kháng xạ ở trẻ em (30/09/2025)
- Nghiên cứu sản xuất thức ăn công nghiệp ương nuôi tôm hùm bông (Panulirus ornatus) giai đoạn ấu trùng puerulus đến con giống 20g/con (30/09/2025)
- Việt Nam tiên phong xây dựng khung pháp lý cho trí tuệ nhân tạo với Luật AI (29/09/2025)
- Nghiên cứu giải pháp khoa học công nghệ thủy lợi nông lâm kết hợp nhằm cải tạo và khai thác đất cát ven biển phục vụ sản xuất nông nghiệp bền vững (29/09/2025)




















